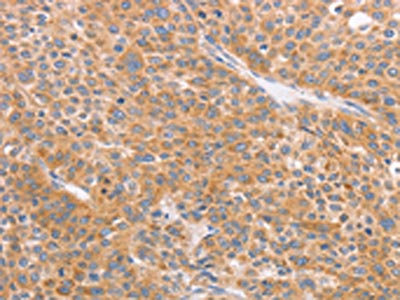

CD2AP Antibody
-
中文名稱:CD2AP兔多克隆抗體
-
貨號:CSB-PA126362
-
規格:¥1100
-
圖片:
-
The image on the left is immunohistochemistry of paraffin-embedded Human thyroid cancer tissue using CSB-PA126362(CD2AP Antibody) at dilution 1/70, on the right is treated with synthetic peptide. (Original magnification: ×200)
-
The image on the left is immunohistochemistry of paraffin-embedded Human liver cancer tissue using CSB-PA126362(CD2AP Antibody) at dilution 1/70, on the right is treated with synthetic peptide. (Original magnification: ×200)
-
Gel: 6%SDS-PAGE, Lysate: 40 μg, Lane 1-2: A431 cells, Raji cells, Primary antibody: CSB-PA126362(CD2AP Antibody) at dilution 1/1000, Secondary antibody: Goat anti rabbit IgG at 1/8000 dilution, Exposure time: 1 second
-
-
其他:
產品詳情
-
Uniprot No.:
-
基因名:
-
別名:Adapter protein CMS antibody; AL024079 antibody; C78928 antibody; Cas ligand with multiple SH3 domains antibody; CD2 associated protein antibody; CD2-associated protein antibody; CD2AP antibody; CD2AP_HUMAN antibody; CMS antibody; Mesenchyme to epithelium transition protein with SH3 domains 1 antibody; METS 1 antibody; Mets1 antibody
-
宿主:Rabbit
-
反應種屬:Human
-
免疫原:Synthetic peptide of Human CD2AP
-
免疫原種屬:Homo sapiens (Human)
-
標記方式:Non-conjugated
-
抗體亞型:IgG
-
純化方式:Antigen affinity purification
-
濃度:It differs from different batches. Please contact us to confirm it.
-
保存緩沖液:-20°C, pH7.4 PBS, 0.05% NaN3, 40% Glycerol
-
產品提供形式:Liquid
-
應用范圍:ELISA,WB,IHC
-
推薦稀釋比:
Application Recommended Dilution ELISA 1:2000-1:10000 WB 1:1000-1:5000 IHC 1:100-1:300 -
Protocols:
-
儲存條件:Upon receipt, store at -20°C or -80°C. Avoid repeated freeze.
-
貨期:Basically, we can dispatch the products out in 1-3 working days after receiving your orders. Delivery time maybe differs from different purchasing way or location, please kindly consult your local distributors for specific delivery time.
-
用途:For Research Use Only. Not for use in diagnostic or therapeutic procedures.
相關產品
靶點詳情
-
功能:Seems to act as an adapter protein between membrane proteins and the actin cytoskeleton. In collaboration with CBLC, modulates the rate of RET turnover and may act as regulatory checkpoint that limits the potency of GDNF on neuronal survival. Controls CBLC function, converting it from an inhibitor to a promoter of RET degradation. May play a role in receptor clustering and cytoskeletal polarity in the junction between T-cell and antigen-presenting cell. May anchor the podocyte slit diaphragm to the actin cytoskeleton in renal glomerolus. Also required for cytokinesis. Plays a role in epithelial cell junctions formation.
-
基因功能參考文獻:
- CD2AP is an sporadic-Alzheimer's-disease risk gene in a southern Chinese Han population. PMID: 28392172
- data suggest that CD2AP acts as a negative regulator of ICAM-1 clustering, which limits the formation of ICAM-1 adhesion complexes to prevent uncontrolled neutrophil adhesion and transcellular transmigration. PMID: 28484055
- CD2AP expression in renal tubules may histologically associate with tissue hypoxia and reflected recovery from CsA-mediated renal injury in nephrotic syndrome patients. PMID: 26975192
- Silencing Cindr in nephrocytes led to dramatic nephrocyte functional impairment and shortened life span, as well as collapse of nephrocyte lacunar channels and effacement of nephrocyte slit diaphragms. These phenotypes could be rescued by expression of a wild-type human CD2AP gene, but not a mutant allele derived from a patient with CD2AP-associated NS. PMID: 28164240
- Study found a novel association of CD2AP with plasma homocysteine in participants with African ancestry and found a new variant in the candidate gene CBS associated with homocysteine PMID: 26519441
- CD2AP rs9349407 polymorphism contributes to Alzheimer's disease susceptibility. PMID: 25092125
- discovered novel interaction candidates for CD2AP and characterized subtle yet significant differences in the recognition preferences of its three SH3 domains for c-CBL, ALIX, and RIN3 PMID: 26296892
- we present the first demonstration that the purified SH3 domains of the CD2AP/Cin85 protein family are able to directly bind the p53 protein, and to discriminate between the two polymorphic variants P72R PMID: 25261582
- CD2-Associated Protein affects Abeta levels and Abeta42/Abeta40 ratio in vitro PMID: 25887956
- CD2AP gene variants may contribute to susceptibility to end-stage renal disease in patients with type 1 diabetes. PMID: 23681557
- FSGS3/CD2AP has a role of barbed-end capping in junctional actin dynamics. PMID: 24322428
- E2F1 up-regulates the human CD2AP promoter. PMID: 22880102
- CD2AP is highly expressed in human plasmacytoid dendritic cells (DC) and positively regulates blood DC antigen 2 (BDCA2)/Fc fragment of IgE high affinity I receptor (FcepsilonR1gamma) signaling. PMID: 22706086
- identifies CD2AP as the gatekeeper of the podocyte TGF-beta response through its regulation of CatL expression and defines a molecular mechanism underlying proteinuric kidney disease PMID: 21911934
- found that the N-terminal SH3 domain of both adaptor proteins CD2AP and CIN85 are the most stable SH3 domains that have been studied until now PMID: 21519904
- found independent evidence for association for Alzheimer's disease susceptibility loci at EPHA1, CD33 and CD2AP PMID: 21460840
- Common variants at MS4A4/MS4A6E, CD2AP, CD33 and EPHA1 are associated with late-onset Alzheimer's disease. PMID: 21460841
- Coexpression of CIN85/Ruk(L) with CD2AP led to a decreased binding of CIN85/Ruk(L) to nephrin and podocin, which indicates a functional competition between CD2AP and CIN85/Ruk(L). PMID: 20457601
- Data identify CD2AP as a novel Rac1-associated adapter protein that participates in the regulation of epithelial cell-cell contact. PMID: 20404345
- The authors report that CD2AP, an endocytosis-associated and cortactin-binding protein, is a novel and important component of enteropathogenic Escherichia coli pedestal formation that also utilizes Y474 phosphorylation of the bacterial Tir. PMID: 20515931
- The absence of mutations of CD2AP in this study suggests that there are other genetic causes of steroid-resistant nephrotic syndrome PMID: 19956976
- CD2AP, through facilitating conjugate formation and directed transport of lytic granules, plays an important role in NK cells killing. PMID: 19945749
- PSTPIP1 acts downstream of CD2/CD2AP to link CD2 engagement to the WASp-evoked actin polymerization required for synapse formation and T cell activation. PMID: 12530983
- Cd2 antigen is linked to CAPZ via this protein and CIN85 PMID: 12690097
- two patients with focal segmental glomerulosclerosis had a mutation predicted to ablate expression of one CD2AP allele, implicating CD2AP as a determinant of human susceptibility to glomerular disease PMID: 12764198
- exposure to normal and non-nephrotic human plasma leads to a concentration of nephrin, podocin, CD2AP, and actin at the cell surface in podocytes PMID: 15659563
- CD2AP is involved in cytokinesis. PMID: 15800069
- CD2AP has a role in the regulation of the actin cytoskeleton PMID: 16707503
- CFBP is a novel tyrosine-phosphorylated protein that might function as a regulator of CIN85/CD2AP PMID: 16895919
- structures support the notion that, despite clear differences in the interaction surface, both Cbl-b and CD2 can mediate multimerization of N-terminal CMS SH3 domains PMID: 17020880
- This work indicates the solution structure of CMS_SH3_B bears the canonical beta-beta-beta-beta-alpha-beta fold and a new binding site in c-Cbl involved in its interaction with CMS, which probably contributes to the clustering of CMS. PMID: 17188587
- CIN85 is expressed as multiple isoforms that share the coiled-coil domain, suggesting that heterotypic interactions with CMS provides a mechanism to regulate CMS binding to F-actin and thus for modulating dynamic rearrangements of the cytoskeleton. PMID: 17606992
- Focal segmental glomerulosclerosis in a patient homozygous for a CD2AP mutation. PMID: 17713465
- identified a polyproline-arginine sequence in the pTalpha cytoplasmic tail that interacted in vitro with SH3 domains of the CIN85/CMS family of adaptors, and mediated the recruitment of multiprotein complexes involving all (CMS, CIN85, and CD2BP3) members PMID: 17823309
- The three-dimensional structure of CD2AP SH3-C contains all the features that are typically found in other SH3 domains, including the general binding site for the recognition of polyproline sequences. PMID: 17922258
- promotor activity in rental tubular epithelial cells is regulated by CREB and Sp1 PMID: 18396147
- Sp1/Sp3 binding sites play a critical role in the CD2AP regulation. PMID: 18791326
- CD2AP mutations modify the interaction with CD2 in lymphocytes and alter the composition of the renal slit diaphragm. PMID: 19131354
顯示更多
收起更多
-
相關疾病:Focal segmental glomerulosclerosis 3 (FSGS3)
-
亞細胞定位:Cytoplasm, cytoskeleton. Cell projection, ruffle. Cell junction.
-
組織特異性:Widely expressed in fetal and adult tissues.
-
數據庫鏈接:
Most popular with customers
-
-
YWHAB Recombinant Monoclonal Antibody
Applications: ELISA, WB, IHC, IF, FC
Species Reactivity: Human, Mouse, Rat
-
Phospho-YAP1 (S127) Recombinant Monoclonal Antibody
Applications: ELISA, WB, IHC
Species Reactivity: Human
-
-
-
-
-